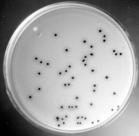
合球菌

簡介
致病性葡萄球菌到處都有,健康成人前鼻孔帶此菌的約占30%,在皮膚上帶此菌的約20%.醫院病人和工作人員的帶菌率略高.在醫院和社區,耐抗生素菌株常見.
| 合球菌 |
 合球菌
合球菌新生兒和餵奶的母親好發葡萄球菌感染,而流感,慢性支氣管肺部疾患(如囊性纖維性變,肺氣腫),白血病,腫瘤,器官移植,假體或其他異物,燒傷,慢性皮膚疾病,手術切口,糖尿病以及血管內塑膠導管留置的病人,也容易受此菌感染.接受腎上腺皮質類固
合球菌
合球菌某些葡萄球菌性疾病是毒素介導的,而並非感染本身所致.葡萄球菌性食物中毒由攝入預先形成的熱穩定性葡萄球菌內毒素所致(參見第28節).由外毒素引起的中毒性休克綜合徵
 合球菌
合球菌(見下文)的發生可能與使用陰道棉塞有關,或是一種手術後感染(常很少引起注意)的併發症.由毒性表皮脫落素所致的葡萄球菌燙傷皮膚綜合徵(staphylococcal scalded skinsyn DROME)是一種小兒的剝脫性皮炎
